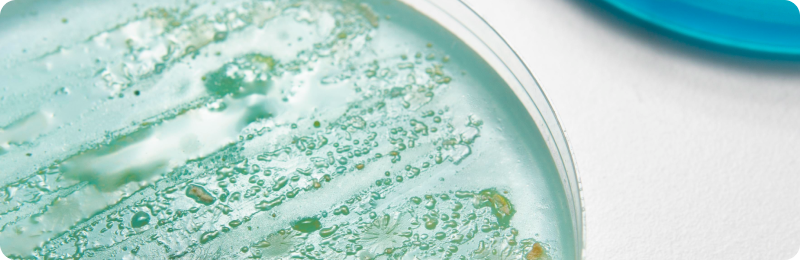

Культивирование анаэробных бактерий — одна из самых технологически насыщенных и важных процедур современной микробиологии. Облигатные анаэробы встречаются в медицине, пищевой промышленности, ветеринарии; их выделение и идентификация критичны для клинической диагностики, санитарных и научных целей. Для воспроизводимого и эффективного получения культуры анаэробов применяются системы от классических анаэростатов до современных газогенерирующих пакетов, что позволяет адаптировать технологию под задачи и бюджет лаборатории.
Принципы и методы создания анаэробных условий
Жизнедеятельность облигатных анаэробов подавляется даже при очень малых концентрациях кислорода. Поэтому основа успешного культивирования — строгий контроль кислородного режима.
Физические методы
- Выращивание в глубине плотных сред — классика: посевы проводят в расплавленный агар или в высокие слои питательной среды, ограничивая доступ воздуха к клеткам. Перед посевом питательные среды кипятят для удаления растворённого кислорода.
- Механическое удаление воздуха (анаэростаты) — специальные герметичные камеры, где воздух откачивается насосом. Современные анаэростаты часто сочетают откачку воздуха с заполнением сосудов инертными газами (азот, углекислый газ) и палладиевым катализатором для связывания остатков кислорода с водородом (образуется вода).
Химические методы
- Генерация бескислородной среды внутри эскикаторов или специальных пакетов — за счет химических реагентов, поглощающих кислород: обычно используется смесь сульфитных или ферромагнитных элементов, также выпускаются готовые газогенерирующие наборы.
- Биологические методы
- Использование быстрорастущих аэробных метаболизаторов (например, Bacillus subtilis) для поглощения кислорода в замкнутой среде. Подход редко применяется в клинической практике и преимущественно интересен для базовых лабораторий.
Современные технологии: от анаэростата до индивидуального пакета
Классические анаэростаты
- Представляют собой металлические сосуды с герметичной крышкой, манометром и вакуум-краном для опыта.
- Позволяют перераспределять атмосферу (создавать искусственную газовую смесь) и поддерживать постоянные анаэробные условия в течение многих суток.
- Оснащаются катализатором (обычно палладиевым) и индикатором анаэробных условий для контроля остаточного кислорода.
- Подходят для больших объёмов, массовых посевов, селекционных опытов.
Газогенерирующие пакеты ("Гаспак", "Анаэрогаз", "Кампилогаз")
- Одноразовые системы для культивирования в чашках Петри/пробирках.
- Пакет с реагентами помещается в специальный пластиковый или металлический герметичный контейнер вместе с посевами.
- После активации начинается химическая реакция: поглощается кислород воздуха, выделяется углекислый газ и водород. При наличии палладиевого катализатора водород связывает кислород, образуется вода, а микроклимат становится анаэробным.
- Такой подход удобен для рутинных диагностик, позволяет обрабатывать от одной до нескольких десятков культур одновременно, не требует вакуумных насосов и сложного оборудования.
Микроанаэростаты и индивидуальные мини-боксы
- Мини-форматы анаэростата для единичных чашек, часто на базе прозрачного пластика.
- Используются в сочетании с газогенерирующими таблетками или мешочками, экономят место и подходят лабораториям с низким или средним потоком анализов.
Пошаговый алгоритм культивирования
- Подготовьте свежую, дегазированную питательную среду согласно инструкции по штамму (часто специальные агаровые среды для анаэробов).
- Перенесите материал асептически: минимизируйте контакт с воздухом, используйте стерильный инструментарий.
- Поместите чашки или пробирки в анаэростат/контейнер сразу после засева.
- Добавьте газогенерирующий пакет или активируйте химический генератор (если используется).
- Закройте камеру и инкубируйте при оптимальной для штамма температуре (обычно 35–37°C) нужное время (от 16 до 72 часов или более).
- Контролируйте анаэробность среды по индикатору (например, метиленовый синий или резазурин должны сохранять бесцветное состояние).
- Извлеките культуры только после завершения инкубации — преждевременное открытие камеры нарушает режим.
Современные решения для лабораторий
- Газогенерирующие пакеты ("Анаэрогаз", "Кампилогаз") адаптированы под стандартные объёмы и форматы посуды, не требуют специальной подготовки персонала и расходников.
- Для выращивания микроаэрофильных бактерий (например, кампилобактерии) используются специальные вариации пакетов, поддерживающие одновременно низкий уровень кислорода и достаточную концентрацию CO₂.
Советы по выбору метода
- Для поточного анализа и крупных лабораторий выгодно использовать классические анаэростаты с ресиверами газа.
- Для экспресс-диагностики и малых проб оптимальны современные газогенерирующие пакеты.
- Важно организовать резерв расходников: индикаторов, катализаторов, упаковки для посуды.
- Не экономьте на качестве среды: специализированные питательные добавки значительно увеличивают шансы положительного результата.
Заключение
Переход от классических анаэростатов к газогенерирующим системам существенно расширил возможности микробиологических лабораторий по культивированию анаэробных бактерий. Современные решения позволяют выращивать клинически значимые патогены быстро, безопасно и стандартизированно, делая микроанализ доступным даже в учреждениях с ограниченными ресурсами.
.svg)